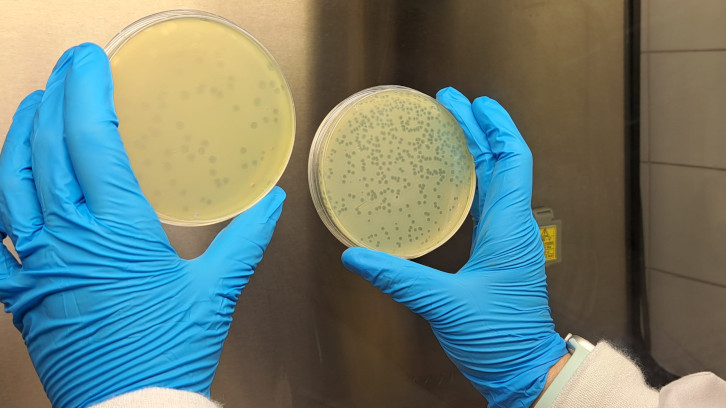
Bacteris en una placa de Petri

Desigualtats en l'activitat física de l'adolescència a Catalunya: influència del nivell socioeconòmic, la immigració i el gènere
Un estudi analitza com el gènere, l’origen i el nivell socioeconòmic i cultural són factors clau que...

Un estudi analitza com el gènere, l’origen i el nivell socioeconòmic i cultural són factors clau que...

El passat novembre va tenir lloc, un any més, el XXIII workshop MRAMA a la UAB per debatre sobre els reptes de la seguretat alimentària. Va comptar amb la participació...

Un estudi del Departament de Ciències de l’Antiguitat i de l’Edat Mitjana ha aconseguit demostrar l’existència de mines d’or al·luvial d’època romana al Pirineu Oriental. Això ha estat possible gràcies a la...

En el món empresarial, qüestionar un lideratge que va en contra de les expectatives socials és complicat per l’estructura jeràrquica existent. Un estudi amb participació del Departament d’Empresa de la UAB ha analitzat com la tendència a...

Un estudi dut a terme per investigadors del CREAF i la UAB ha examinat les bromèlies, una planta tropical que creix en troncs i branques d’arbres, a l’Equador, per analitzar el microhàbitat que s’hi forma entre les seves fulles, on...

Investigadors del Departament d’Empresa de la UAB han participat en un estudi per analitzar la relació entre la inversió de la UE en innovació i recerca mediambiental i l’impacte...

Un estudi del Grup GICOM manifesta la importància de valoritzar els residus de la depuració de les aigües residuals. La recerca proposa la producció de biopesticides a partir del digestat, el residu de la digestió dels primers fangs de les...

Un estudi dut a terme per la UAB i l’Hospital Universitari Parc Taulí ha desenvolupat la classificació Taulí-pT1 per ajudar a concretar quina cirurgia convé més...

Els bacteriòfags es perfilen com una eina innovadora i sostenible per al biocontrol de patògens en la producció animal. Personal investigador de la UAB ha col·laborat en un estudi innovador,...
Un estudi publicat a PLoS ONE revela que la delinqüència contra la propietat a Barcelona segueix una estacionalitat marcada i predictible. Mitjançant una nova metodologia basada en l’entropia i en models de...
